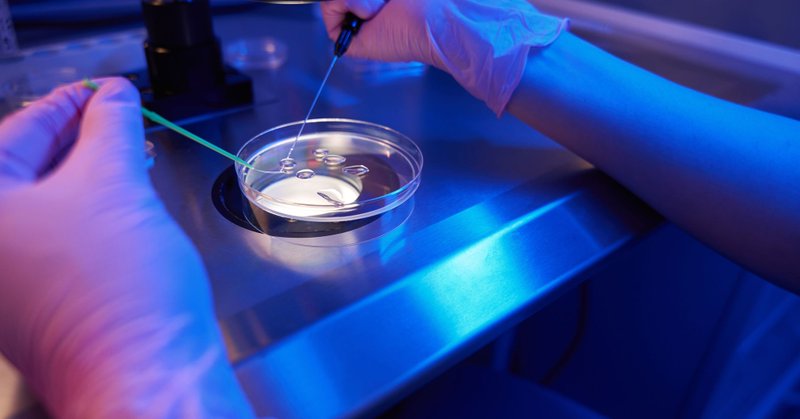
Tweet card summary image

Schuh Lab
@SchuhLab
Followers
6K
Following
811
Media
175
Statuses
492
Illuminating the beginning of life at the Department of Meiosis, @mpi_nat. Account managed by Melina and Vanessa @SchuhLab.
Göttingen, Germany
Joined May 2018
Honored to receive the Falling Walls Science Breakthrough of the Year 2025 (Life Sciences)! 🧬 With Tabea Lilian Marx, Christopher Thomas & our team, we filmed ovulation in real time — a dream come true. 👉 https://t.co/YgQx4loEk0
#FallingWalls #ScienceSummit25
3
9
64
🧬Why does female fertility decline with age? And can egg cells be rejuvenated🥚? Find out in a new interview with Melina discussing her research on the biology of aging #oocytes. #WomensHealth 💜 (Article in German) https://t.co/IpUWeq4RRb
ajour.ch
Immer mehr Frauen bekommen spät Kinder. Die Zellbiologin Melina Schuh erforscht, warum Eizellen im L...
0
1
8
🎉@OvoLabsGmbH won the @EliLillyandCo x @NucleateHQ Grand Challenge 2025! Founded by Melina Schuh, @MissMeiosis & @yagensky to improve IVF success rates, Ovo Labs was picked from 450+ biotech companies. A deserved recognition for impact in #WomensHealth 💜 https://t.co/rVbPj76Egp
nucleatehq.medium.com
The 2025 Lilly Grand Challenge brought together some of the most promising early-stage biotech innovators at Eli Lilly and Company’s global…
2
0
18
Last week, we enjoyed wonderful days on our #labretreat at Ringberg Castle by Lake Tegernsee, together with the @rinklab and @LenartLab. We explored science, hiked, did yoga, played games, and shared lots of laughter. A perfect setting to exchange ideas and connect. 🧠🧘♀️🎲
0
1
15
👉 Dive into our full review to explore these mechanisms in detail, compare strategies across species, and see how understanding protein storage in oocytes could open new paths for fertility research. Thanks to @jentoft_ida for your great work on this review. (5/5)
0
0
1
But oocytes face another challenge: protein damage accumulates during the mother’s life. Proteostasis clears or sequesters damaged proteins, rejuvenating the egg. Failure may explain age-related fertility decline, as long-lived proteins lose stability and clearance falters. (4/5)
1
0
0
Across species, diverse strategies have evolved to store proteins, from large filamentous assemblies to membrane bound compartments. These systems prevent premature degradation and ensure key proteins are available when needed after fertilization. (3/5)
1
0
0
As transcription shuts down in growing oocytes, the egg relies on maternally deposited proteins and RNAs to drive early development, until the embryo can make its own. But how do oocytes store these proteins? (2/5)
1
0
0
How do #oocytes prepare for life before life begins? 🧬 Our new review in Annual Review of Cell and Developmental Biology @annualreview explores how oocytes store proteins to support development and fertility. (1/5) 🔗 https://t.co/nB3UQJSf84
annualreviews.org
Maternal storage is a fundamental feature of female gametes and is essential for maintaining oocyte quality and preserving developmental competence. Embryonic development relies on maternally...
3
9
40
🎥 Our research made it into SWR Wissen, with our PhD student @Tabea_Marx sharing insights. Definitely worth a watch! (Video in German)
Tabea Marx from the Department of Meiosis @SchuhLab talks about the group’s ovulation research in the new SWR Wissen video (in German)! Why is ovulation research so challenging for scientists? What did the team find out? Watch the video to learn more👇 https://t.co/N7axXUETSo
0
1
9
Great honor to be nominated as one of the top 10 Falling Walls Foundation Science Breakthroughs of the Year 2025 in the Life Sciences. A big thank you to @LastChrisThomas & @Tabea_Marx for their outstanding contributions, & to everyone else who helped move this project forward.
Keeping our fingers crossed for you, Melina @SchuhLab! We are thrilled that our director has been nominated for the Falling Walls Foundation Science Breakthroughs of the Year 2025 in the Life Sciences category with her project “Breaking the Wall of Invisible Ovulation”. 🥂 More
0
2
58
Our fantastic technician Kevin marked his 30th birthday 🎉 and of course, the traditional German „fegen“ (sweeping) ritual was part of the celebration. Cheered on by colleagues, he handled it with humor and a great attitude. Welcome to your thirties, Kevin! 🧹🎂🥳
0
0
16
This week, Melina gave the Theodor Boveri Award Lecture at the University of Würzburg, the university’s highest honor in lifesciences. This lecture recognizes outstanding scientists whose work continues Theodor Boveri’s pioneering legacy. Congratulations to Melina for this honor!
1
1
26
Our PostDoc @Debojit_Saha03 recently attended a @cshlcourses & came back with new techniques and stunning images. This mouse E9.5 embryo, labeled with Raldh2 (red), Fgf8 (green), Msx1 (magenta), DAPI (blue) is just one example. #Fluorescence revealing the magic of development!✨
0
7
72
What an inspiring #NachtdesWissens in Göttingen! Thanks to our amazing team, who made our research on oocytes 🥚 fun and accessible for everyone. Great to see so many #curiousminds exploring our science up close and joining in creative activities! 🖍️🧑🔬
0
1
21
Schuh lab is also on @bluesky 🦋 We look forward to meeting you there! Follow us and help to grow that community! https://t.co/2DzoMm3QNc
0
1
8
It was great having @marusiazel @schuhlab for her lab rotation within the IMPRS Molecular Biology Master Program. She presented her project, supervised by Nina, in our large seminar room. Congratulations on sucessfully finishing - well done!🎉#researchtogether #posterpresentation
0
1
24
We had the pleasure of welcoming RTG2756 PhD students from @uniGoettingen to our lab for a hands-on methods course. Great vibes, curious minds, and lots of good science – we truly enjoyed having you with us! 🧪🔬 #PhDLife #ScienceTogether
https://t.co/Nk8WrnCc2Y
0
0
15
Our PhD student Tabea is featured in the latest podcast episode of Forschungsquartett by @detektorfm! She takes us behind the scenes of filming ovulation for the first time.💥 🎧 Grab your headphones & enjoy the story: https://t.co/QMjXHvhVry (🎙️#Podcast in German)
mpg.de
Einem Forschungsteam ist es erstmals gelungen, den gesamten Prozess des Eisprungs in Follikeln einer Maus zu filmen. Was bedeutet das für die Fruchtbarkeitsforschung? Ein Podcast mit Tabea Marx vom...
0
2
12